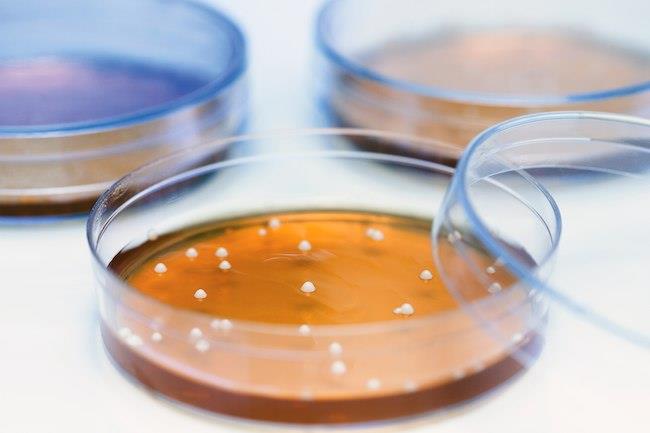

نشعر أحيانا بحكة أو لدغة أو ألم في أجسادنا، ولا نعرف لها سببًا، ثم لاحقا يتضح أنها بسبب حشرات أو ديدان دقيقة تعيش على بشرتنا أو في أمعائنا أو حتى في حلوقنا. الكثير منها لا يُرى بالعين المجردة، وهي تتعايش وتعيش معنا، بعضها مُضر وأخرى غير ضارة وثالثة تختفي من نفسها. نستعرض لكم هنا عددا من الكائنات التي تعيش في أجسادنا ولا نشعر بها في كثير من الأحيان.
1- قمل الرأس:
يمكن لهذه الحشرات الصغيرة أن تعيش في شعرك وتمتص الدم من فروة رأسك، إلا أنها ليست خطيرة بشكل عام، وتشعر بمجرد حكة، إضافة إلى أنها معدية، وشائعة في أطفال المدارس الابتدائية. يمكنك شراء أنواع من الشامبو لتقتلها، ويمكن للطبيب أن يخبرك عن الوصفات الطبية. انتبه فلو كان هناك بيض وفقس، ستصاب بالحكة مجددًا.

2- القوباء الحلقية:
اسمها الإنجليزي يتضمن كلمة "دودة"، لكن لا تقلق فليس هناك ديدان على الإطلاق. إنها فطر يمكن أن يصيب أي جزء من جسمك، كرأسك مثلا، فيتسبب في سقوط الشعر. وقد تصيب قدميك، ويطلَق على هذا النوع اسم "قدم الرياضي"، وتصيب كذلك الجزء العلوي. العلاج هو الكريمات المضادة للفطريات أو البخاخات أو المساحيق أو الحبوب.

3- دودة الإنكلوستوما
يُعد هذا النوع من الديدان نادرا في الولايات المتحدة، حيث تدخل اليرقات الخطافية إلى بشرتك، وعادة ما توجد في آسيا وأفريقيا والشرق الأوسط، وتدخل جسدك إذا مشيت حافي القدمين على التربة المصابة، وهي تعيش في أمعائك، وليست خطرة بشكل عام، وغالبًا تختفي دون علاج. أعراضها حكة واحمرار في البشرة، ويحتمل أن يكون هناك سعال، وأزيز، وألم في المعدة.

4- دودة شريطية:
يمكن أن تصاب بهذا الطفيلي من لحم البقر المصاب، لحم الخنزير، أو الأسماك. إذا كنت مصابا به، فسترى على الأرجح بيضًا صغيرًا وقطعا من الديدان في الشرج، وقد يصل طولها إلى 30 قدمًا بداخلك، وتسبّب الإسهال والتشنجات وفقدان الوزن.

5- عث الوجه:
هي في الأساس عناكب صغيرة تلتقطها مع تقدمك في العمر، وفي سن الستين، يكون لديك ألفان من صغارها التي تعيش على وجهك، إلا أنه لا يمكنك رؤيتها لأنها لا تتعدى طول ثلث مليمتر. ليس هناك ما يدعو للقلق، كل ما يريدونه هو أكل بعض خلايا الجلد الميتة وقليل من الدهون على الوجه.

6- الجرب:
حشرات الجرب تستخدم أقدامها لتحفر في جلدك، سواء كان ذلك في الفخذ أو الإبط أو أصابع قدميك ويحدث حكة جلدية مزعجة، قد تنقل العدوى من شخص لآخر إذا لمست البشرة، أو الفرش أو الملابس أو الأثاث. يستطيع طبيبك تحديد إصابتك، كما يمكن للأدوية بوصفة طبية أن تشفيك منها، كما يجب غسل الفراش والملابس.

7- الجيارديا:
هي طفيليات صغيرة جدا تعيش في أمعائك، تصيبك إذا سبحتَ أو شربتَ من مياه الجداول والبحيرات، أو عن طريق أحواض المياه الساخنة، ومياه الآبار، وحمّامات السباحة، والأطعمة الملوثة، أو الاتصال بشخص مصاب. أعراض الإصابة بها تشنجات وغازات، فقدان الوزن، تجشؤات برائحة الكبريت، وإسهال كريه الرائحة، ويمكن ألا يكون لها أي أعراض.

8- بكتيريا السرّة:
في طيات السرة الخاصة بك، تجعل الغدد العرقَ والزيتَ وأشياء أخرى تجذب بعض البكتيريا وتتصدى لأخرى، وقد يصيبك بعضها بالمرض في أماكن أخرى من جسدك. ولكن في السرة يمكن للبكتيريا أن تساعد في محاربة جراثيم أكثر خطورة. ويمكن لأشياء مثل جنسك، وشكل جسمك، ومكان إقامتك، وجيناتك أن تحدد نوع البكتيريا، وكم سيصيبك منها.

9- الفطريات بيننا:
الفطريات تنمو في أماكن مظلمة ودافئة ورطبة مثل فمك، طيات جلدك، وشعرك، ما يتسبب في طفح جلدي، حكة، وتورم الجلد. يمكن أن تنمو الفطريات في فمك بشكل كبير، وتسبب بقعًا ونتوءات بيضاء على لسانك أو حلقك أو داخل وجنتيك، وقد يسميها طبيبك "القلاع"، ويمكن علاجها بالعقاقير المضادة للفطريات.

10- كائنات دقيقة في الأمعاء:
معظم تريليونات الأشياء المجهرية التي تعيش في جسمك وفي داخله توجد داخل أمعائك، حيث تتفاعل مع كل من نظامك الغذائي، وجسمك، والبيئة المحيطة بك، ولا يزال الباحثون يكتشفون طريقة حدوث ذلك.

11- كائنات في الفم:
هناك توازن دقيق للبكتيريا والفطريات والفيروسات في فمك طوال الوقت، ويمكن أن تبدأ المشاكل مثل التجاويف أو القروح عندما يختل هذا التوازن، بسبب أمور ما، مثل جفاف الفم أو مرض السكري أو ضعف جهاز المناعة.

12- بكتيريا لاكتوباسيلي:
هناك توازن دقيق آخر ومخلوقات مجهرية داخل المهبل، ويُعتقد أنها خط الدفاع الأول ضد الميكروبات الأخرى التي يمكن أن تسبب إفرازات مهبلية وحكة كريهة. البكتيريا العصبية "لاكتوباسيلي"، خاصة، تعزز صحة المهبل بالمساعدة على الحفاظ على مستويات الحمض صحيحة، ما يساعد في منع الالتهابات المهبلية البكتيرية.
13- ميكروبات الإبط:
توازن الكائنات ليس فقط في الفم والأمعاء، فحتى الإبطان لديهما ميكروب، وهو جزء من سبب الرائحة الصادرة منهما، وغالباً تكون بكتيريا "العنقوديات" التي يُعتقَد أنها تقاوم الجراثيم الأخرى. لكن المزيج يتغير بشكل كبير إذا كنت تستخدم مضادًا للعرق.





































































